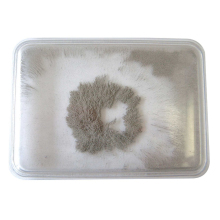
Iron Filings in Case

Plastic Cased Magnets
Pack of 2
Product Code
CM50028
$16.90
$19.44
Strong magnets in a tough plastic casing for use in all manner of classroom scientific activities and discoveries.
- Pack of 2
- Colour coded: red for North and blue for South
- Size: 8 x 2.2 x 1cm
| Display In Stock In Frontend | No |
|---|
Write Your Own Review